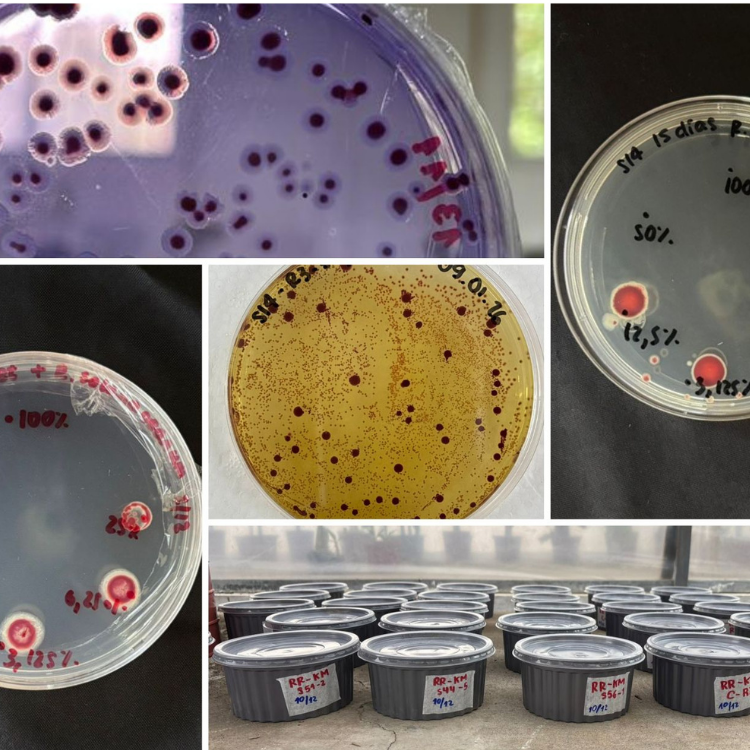

Pósters: Facultad de Ciencias de la Vida

Ingeniería Agrícola y Biológica
Dimensionamiento de un sistema de bombeo solar fotovoltaico para la agricultura a pequeña escala.
Reinoso Cervantes Carlos AndrÉ
ODS asociados:

Ingeniería Agrícola y Biológica
Diseño metodológico del uso de Trinexapac etil en semilleros de caña de azúcar en Guayas
Robalino Velez Juan Sebastian
ODS asociados:

Ingeniería Agrícola y Biológica
Evaluación del estado estructural arbóreo en el Bosque Prosperina mediante índices de vegetación.
Orlandini Haz Antonio Jose
ODS asociados:

Ingeniería Agrícola y Biológica
Impacto de tratamientos con biosólidos sobre el rendimiento/parámetros agronómicos del maíz en suelos degradados
Garcia Arana Enrique Jose
ODS asociados:
Ingeniería Agrícola y Biológica
Potencial de actinobacterias como alternativa biológica sostenible para el control del Moko bacteriano (Ralstonia solanacearum)
Rivera Cerezo Rachel Kristhyna
ODS asociados:

Licenciatura en Nutrición y Dietética
Aplicación móvil para el manejo nutricional de síntomas y efectos secundarios en pacientes oncológicos pediátricos
Menoscal Sanchez Arianna Belen, Mogrovejo Moran Aileen Ninoska
ODS asociados:

Licenciatura en Nutrición y Dietética
Caracterización antropométrica, composición corporal y hábitos alimentarios en futbolistas jóvenes del Guayaquil City Fútbol Club.
Crespin Lay Gianela Natalia, Ledesma NuÑez Ronald Antonio
ODS asociados:

Licenciatura en Nutrición y Dietética
Caracterizar la fuerza prensil, calidad de vida en mujeres con cáncer de mama.
Chimbo Sanmartin Geomary Thaily, Aguilar Gonzalez Victoria Maria
ODS asociados:

Licenciatura en Nutrición y Dietética
Comparación de etiquetados nutricionales y percepción de riesgo de nutrientes críticos en profesores de ESPOL.
Rivas Moreira Cristina Antonella, Valverde Yepez Javier Isaias
ODS asociados:

Licenciatura en Nutrición y Dietética
Conocimiento de nutrición deportiva en estudiantes de una universidad guayaquileña y producción de un pódcast.
Lopez Alvarez Fernando Isaac, Rocohano Lavayen Jeffrey Josue
ODS asociados: